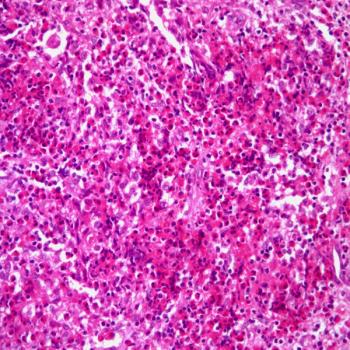

A 36-year-old man presents with a painless right arm mass. What is your diagnosis?

Your AI-Trained Oncology Knowledge Connection!


A 48-year-old woman presents with a mass in the right kidney. What is your diagnosis?
A 23-year-old patient is found to have a “lump” on the left clavicle during a routine physical exam. Resection of the lump was performed. What is your diagnosis?

A 62-year-old man presents with painless jaundice. ERCP and CT images are shown below. What is your diagnosis?

A 19-year-old woman presents with anterior cervical area lymphadenopathy. After further evaluation, a lymph node biopsy is performed. What is your diagnosis?

A 27-year-old woman, postpartum, presents with vaginal bleeding. What is your diagnosis?

A 28-year-old woman presents with a 2-cm nodule on her left arm. What is your diagnosis?
.jpg?w=350&fit=crop&auto=format)
A 48-year-old man presents with diffuse lymphadenopathy. After further evaluation, a biopsy is performed. What is your diagnosis?
.jpg?w=350&fit=crop&auto=format)
A 40-year-old woman is found to have several nodules in the liver. After further evaluation, a biopsy is performed. What is your diagnosis?

A 52-year-old woman presents with a right kidney mass. What is your diagnosis?

A 68-year-old woman with a history of aggressive NHL developed hyperpigmented patches on her tongue two months after starting her R-CHOP chemotherapy regimen. Which medication was likely the cause, and which other location would you expect hyperpigmentation on this patient?

A 68-year-old man presents with a dark lesion on his forehead. A surgical resection is performed. What is your diagnosis?
.jpg?w=350&fit=crop&auto=format)
A 54-year-old man is found to have a mass in the upper pole of the right kidney. After further evaluation, a biopsy is performed. What is your diagnosis?

A 52-year-old man with a history of heavy alcohol use and chronic abdominal pain presents with the following CT scan. What is your diagnosis?
.jpg?w=350&fit=crop&auto=format)
A 34-year-old man presents with symptoms of appendicitis which required having his appendix removed. What is your diagnosis?

A 63-year-old man presents with pain in the right arm. A lesion in the humerus is identified and a biopsy is taken. What is your diagnosis?
.jpg?w=350&fit=crop&auto=format)
A 27-year-old man is found to have an anterior mediastinal mass. A biopsy of the mass is performed. What is your diagnosis?

A 28-year-old man presents with a mass in his right testicle. What is your diagnosis?
.jpg?w=350&fit=crop&auto=format)
A 42-year-old woman is found to have a left breast nodule. A breast biopsy is performed. What is your diagnosis?

A 57-year-old man presents with symptoms of pain in the sacral area. A mass is resected. What is your diagnosis?